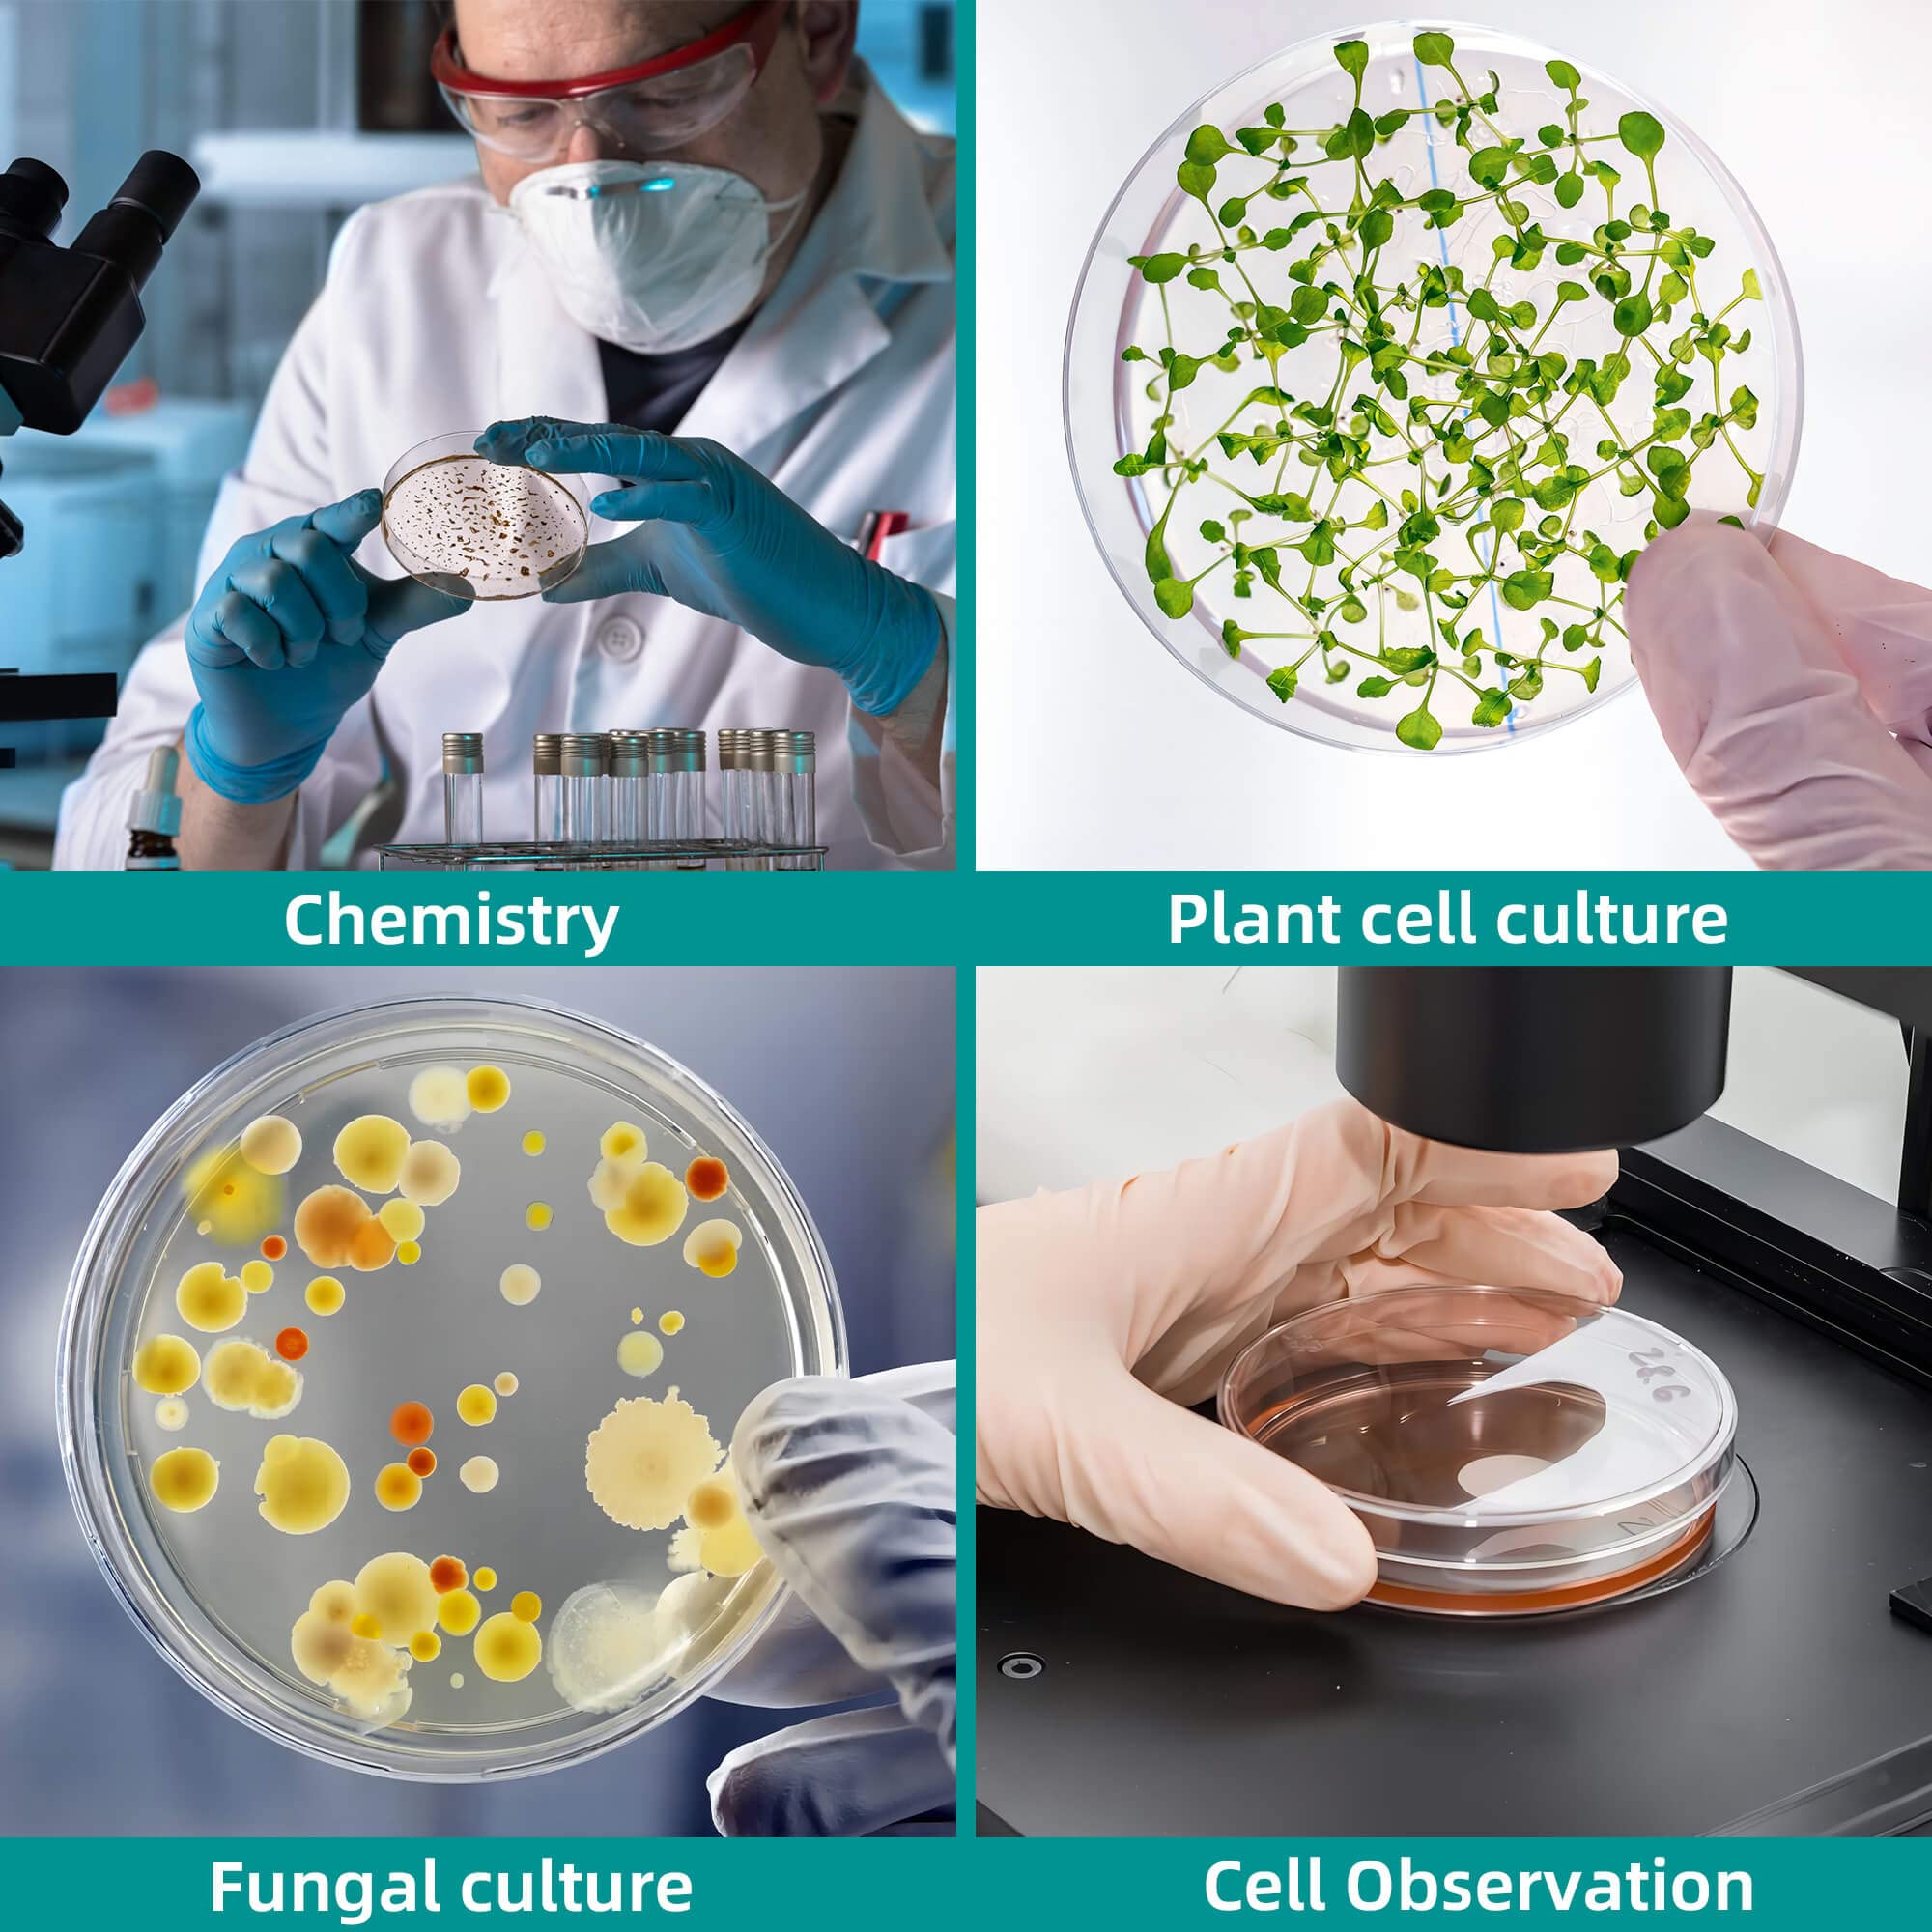
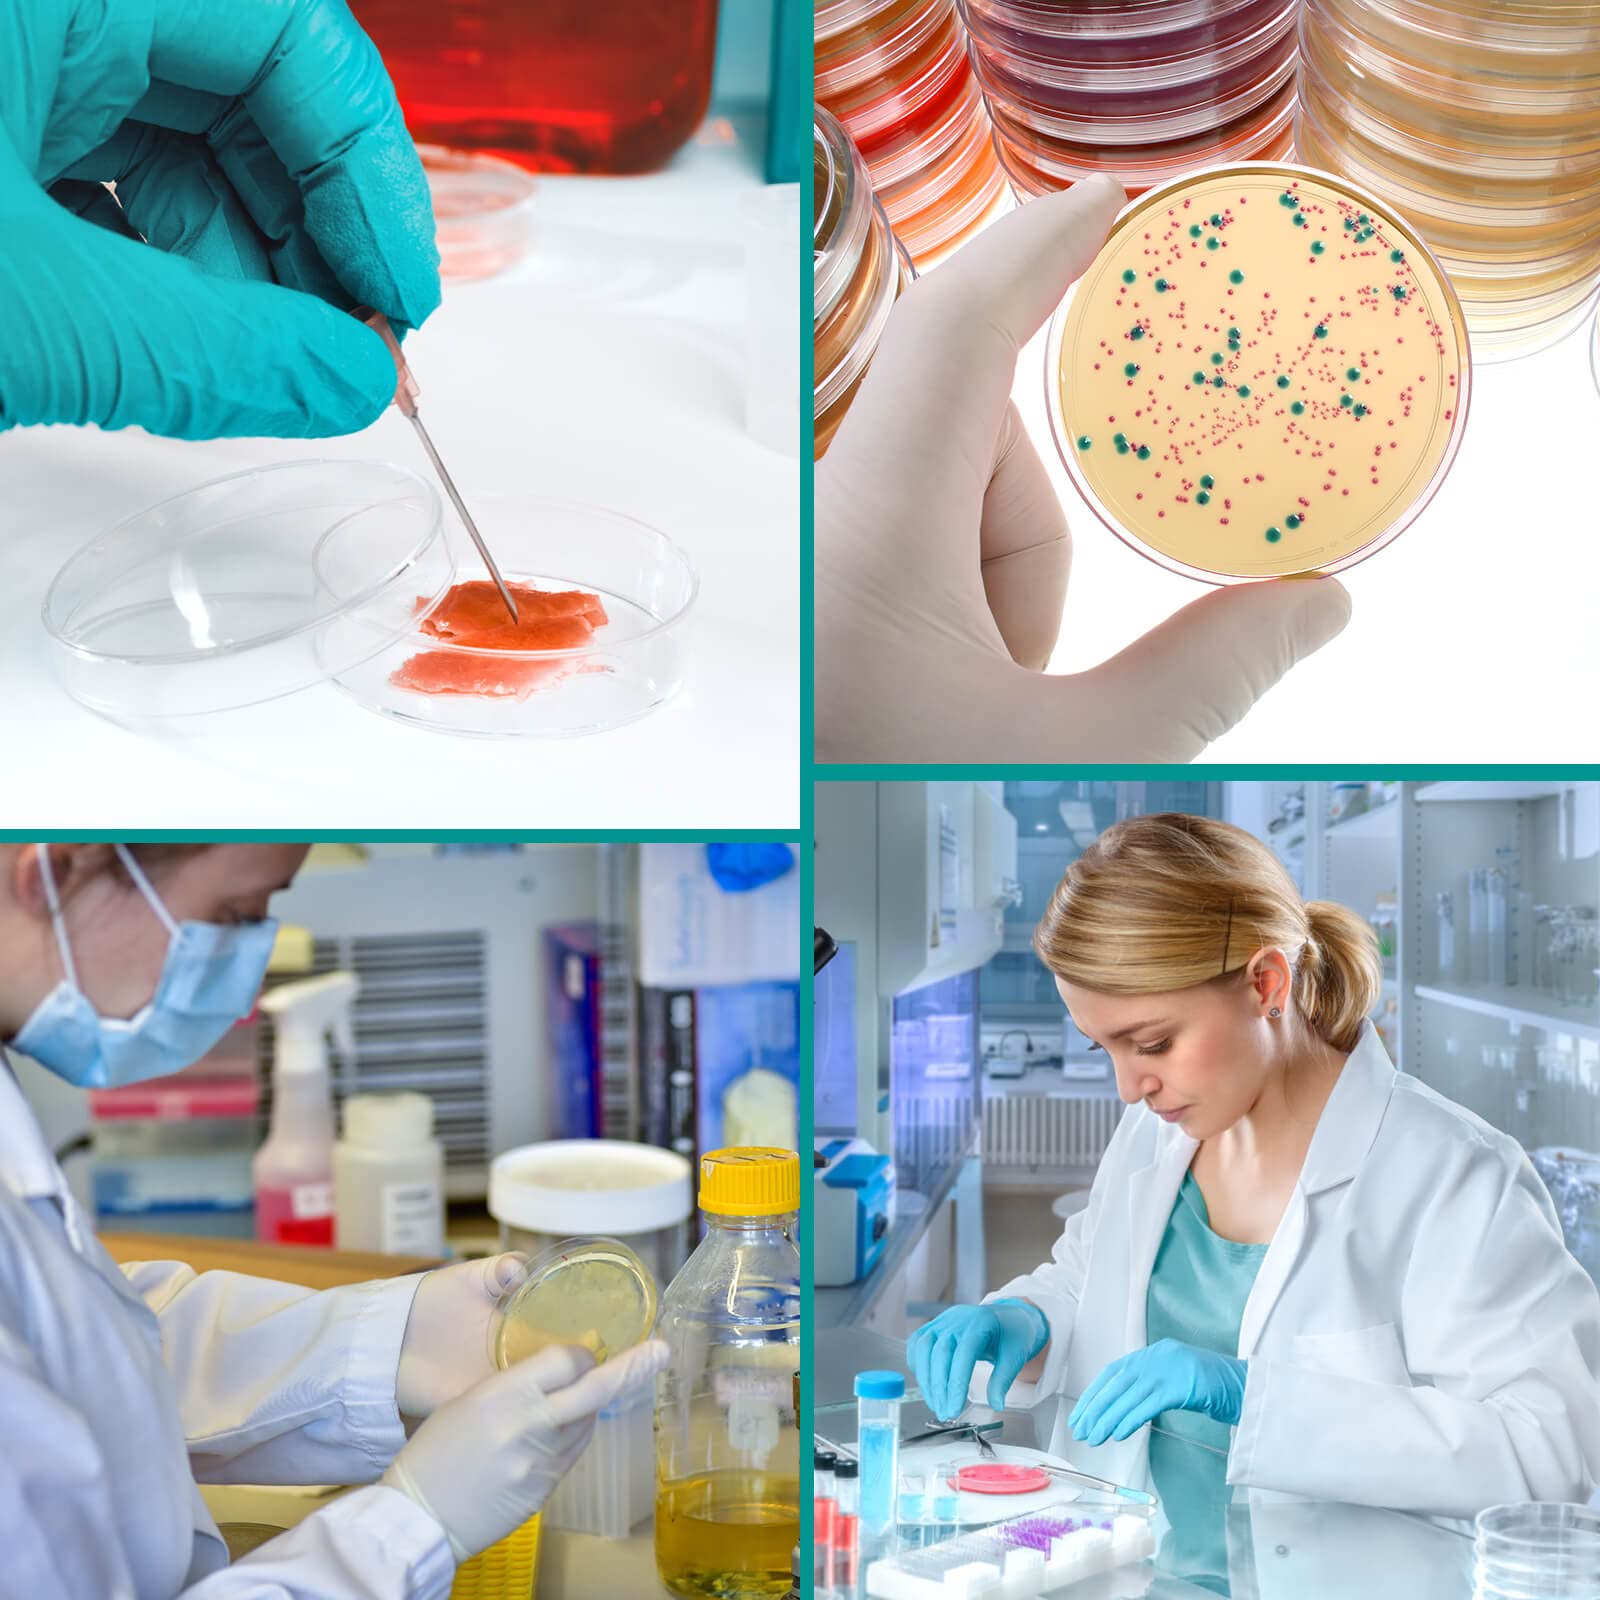

Auction Ended
24 Pack Sterile Plastic Petri Dishes with Lid [Upgrade Thickness] 90mm Dia x 15mm Deep Clear Petri Dish for Lab Analysis, School Projects, Blood Samples, Bacteria, Microbial & Seed Cell Culture Dishe
Sold
Good Condition
QTY 1
$0.10
MSRP
MSRP is a sample online retail price.
$9.00
Last Update:
10/27/2025, 7:52 PM ESTItem Information
MSRP:
MSRP is a sample online retail price.
$9.00
Brand:
EDC-BFYOU
Condition:
Good Condition
Description:
petri dish, agar plates, petri dishes with agar, petri dishes, petri dishes with lids, agar agar petri dishes, sterile petri dishes, agar plates mycology, petri dish glass, malt extract agar, bacteria growing kit, mycology supplies
Lot Code:
ORG5760562
Width:
7.7 inches
Depth:
4.1 inches
Weight:
1.1 pounds
Length:
8.3 inches
Additional Info:
Good Condition
Pickup Location:
333 West Seymour Ave., Cincinnati OH 45216
Warehouse Location:
7
Auction Number
SEY2400543